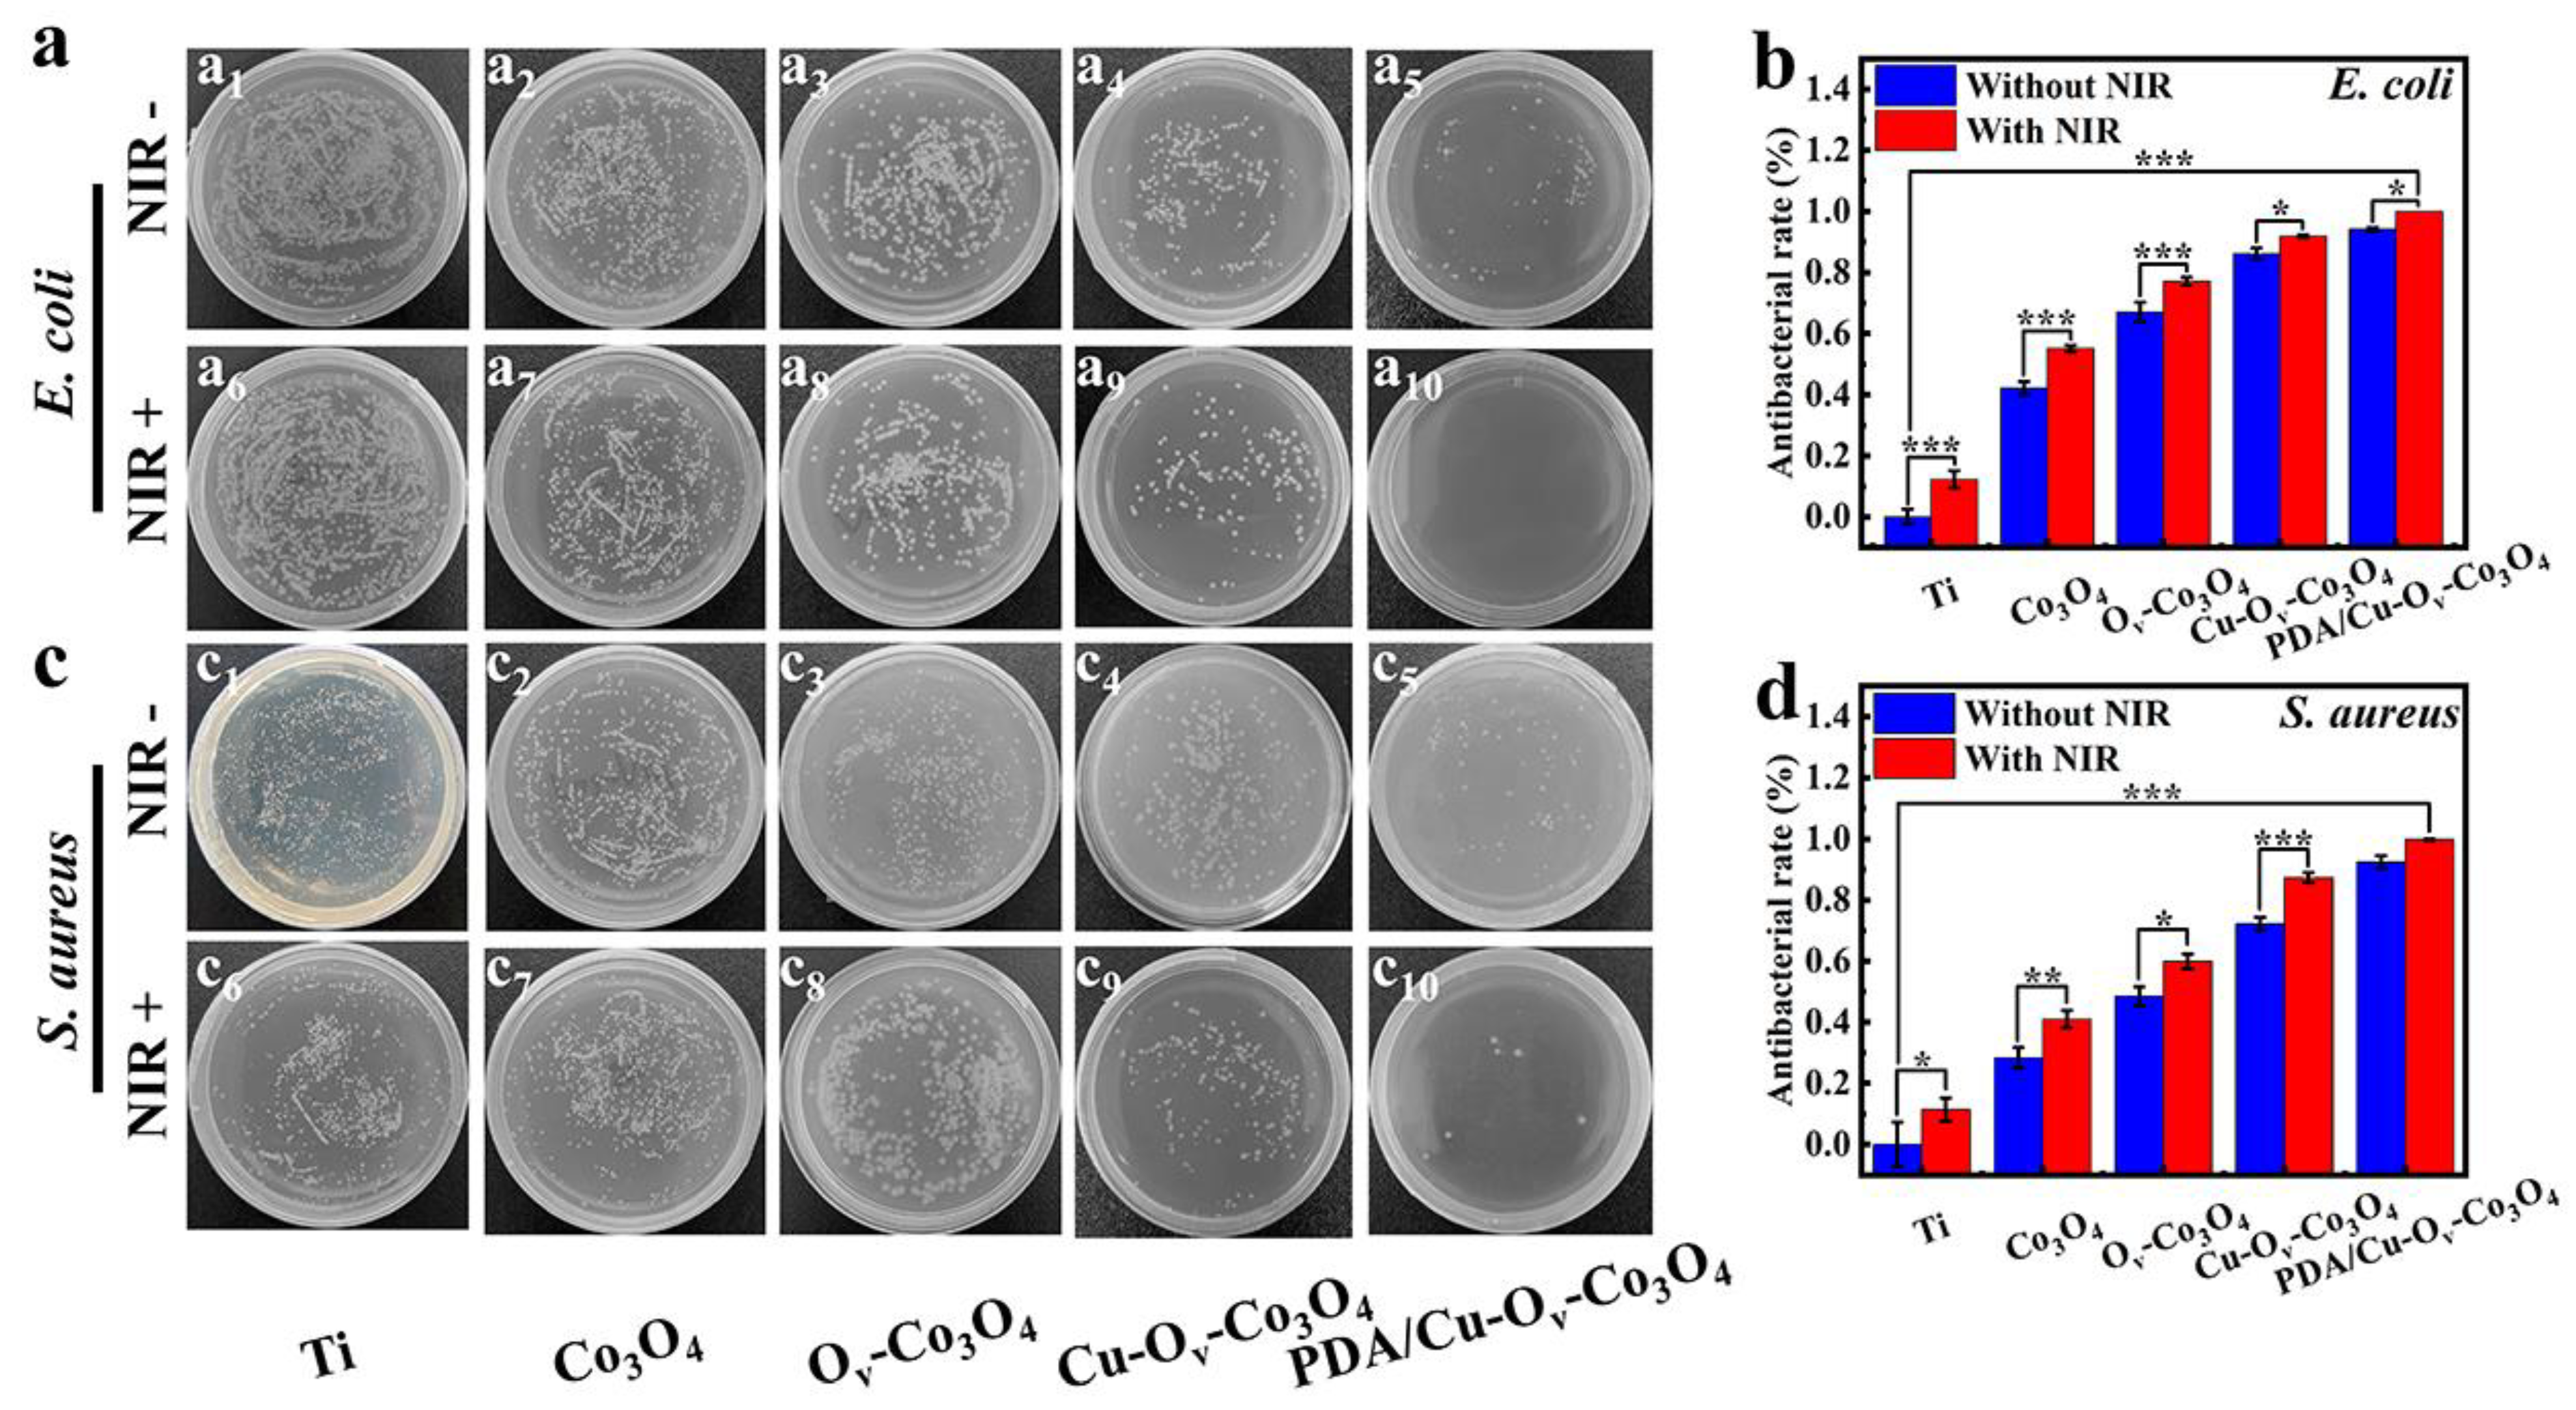
Materials 17 02019 g005

Polydopamine-Coated Copper-Doped Co3O4 Nanosheets Rich in Oxygen Vacancy on Titanium and Multimodal Synergistic Antibacterial Study
Abstract
1. Introduction
2. Materials and Methods
2.1. Materials
2.2. Characterization
2.3. Synthesis of Co3O4 Nanosheets on Ti foils
2.4. Fabrication of Ov-Co3O4 and Cu-Ov-Co3O4 Nanocoatings
2.5. Preparation of PDA/Cu-Ov-Co3O4 Nanocoatings
2.6. Photothermal Experiment
2.7. Antibacterial Activity Assessment
2.8. Analysis of Antibacterial Mechanism
2.8.1. Bacterial Membrane Permeability Assay
2.8.2. Bacterial Total ROS Level Detection
2.8.3. Singlet Oxygen Measurement
2.8.4. Hydroxyl Radical Evaluation
2.8.5. Bacterial Protein Leakage Assay
2.8.6. Bacterial ATP Level Test
2.9. Metal Ion Release Test
2.10. Cytotoxicity Evaluation
3. Results and Discussions
3.1. Synthesis and Physicochemical Properties
3.2. Photothermal Performance
3.3. Antibacterial Activity
3.4. Cell Compatibility
3.5. Synergistic Antibacterial Mechanism
4. Conclusions
Supplementary Materials
Author Contributions
Funding
Institutional Review Board Statement
Informed Consent Statement
Data Availability Statement
Conflicts of Interest
References
- Yuan, Z.; Tao, B.; He, Y.; Mu, C.; Liu, G.; Zhang, J.; Liao, Q.; Liu, P.; Cai, K. Remote eradication of biofilm on titanium implant via near-infrared light triggered photothermal/photodynamic therapy strategy. Biomaterials 2019, 223, 119479. [Google Scholar] [CrossRef] [PubMed]
- Abd-Elaziem, W.; Darwish, M.A.; Hamada, A.; Daoush, W.M. Titanium-Based alloys and composites for orthopedic implants Applications: A comprehensive review. Mater. Des. 2024, 241, 112850. [Google Scholar] [CrossRef]
- Kelly, C.N.; Wang, T.; Crowley, J.; Wills, D.; Pelletier, M.H.; Westrick, E.R.; Adams, S.B.; Gall, K.; Walsh, W.R. High-strength, porous additively manufactured implants with optimized mechanical osseointegration. Biomaterials 2021, 279, 121206. [Google Scholar] [CrossRef] [PubMed]
- Lin, M.-H.; Wang, Y.-H.; Kuo, C.-H.; Ou, S.-F.; Huang, P.-Z.; Song, T.-Y.; Chen, Y.-C.; Chen, S.-T.; Wu, C.-H.; Hsueh, Y.-H.; et al. Hybrid ZnO/chitosan antimicrobial coatings with enhanced mechanical and bioactive properties for titanium implants. Carbohydr. Polym. 2021, 257, 117639. [Google Scholar] [CrossRef] [PubMed]
- Xie, X.; Mao, C.; Liu, X.; Zhang, Y.; Cui, Z.; Yang, X.; Yeung, K.W.K.; Pan, H.; Chu, P.K.; Wu, S. Synergistic Bacteria Killing through Photodynamic and Physical Actions of Graphene Oxide/Ag/Collagen Coating. ACS Appl. Mater. Interfaces 2017, 9, 26417–26428. [Google Scholar] [CrossRef] [PubMed]
- Blair, J.M.A.; Webber, M.A.; Baylay, A.J.; Ogbolu, D.O.; Piddock, L.J.V. Molecular mechanisms of antibiotic resistance. Nat. Rev. Microbiol. 2015, 13, 42–51. [Google Scholar] [CrossRef] [PubMed]
- Hughes, D.; Andersson, D.I. Evolutionary Trajectories to Antibiotic Resistance. Annu. Rev. Microbiol. 2017, 71, 579–596. [Google Scholar] [CrossRef] [PubMed]
- Fang, J.; Wan, Y.; Sun, Y.; Sun, X.; Qi, M.; Cheng, S.; Li, C.; Zhou, Y.; Xu, L.; Dong, B.; et al. Near-infrared-activated nanohybrid coating with black phosphorus/zinc oxide for efficient biofilm eradication against implant-associated infections. Chem. Eng. J. 2022, 435, 134935. [Google Scholar] [CrossRef]
- Avcu, E.; Bastan, F.E.; Guney, M.; Yildiran Avcu, Y.; Ur Rehman, M.A.; Boccaccini, A.R. Biodegradable Polymer Matrix Composites Containing Graphene-Related Materials for Antibacterial Applications: A Critical Review. Acta Biomater. 2022, 151, 1–44. [Google Scholar] [CrossRef] [PubMed]
- Yeroslavsky, G.; Lavi, R.; Alishaev, A.; Rahimipour, S. Sonochemically-Produced Metal-Containing Polydopamine Nanoparticles and Their Antibacterial and Antibiofilm Activity. Langmuir 2016, 32, 5201–5212. [Google Scholar] [CrossRef]
- Fu, Y.; Yang, L.; Zhang, J.; Hu, J.; Duan, G.; Liu, X.; Li, Y.; Gu, Z. Polydopamine antibacterial materials. Mater. Horiz. 2021, 8, 1618–1633. [Google Scholar] [CrossRef] [PubMed]
- Li, C.; Li, Z.; Zeng, Y.; Cao, X.; Zhao, H.; Yang, Y.Y.; Yuan, P.; Lu, X.; Ding, X. Co3O4 Nanowires Capable of Discharging Low Voltage Electricity Showing Potent Antibacterial Activity for Treatment of Bacterial Skin Infection. Adv. Healthc. Mater. 2022, 11, 2102044. [Google Scholar] [CrossRef]
- Tian, Y.; Yao, S.; Zhou, L.; Hu, Y.; Lei, J.; Wang, L.; Zhang, J.; Liu, Y.; Cui, C. Efficient removal of antibiotic-resistant bacteria and intracellular antibiotic resistance genes by heterogeneous activation of peroxymonosulfate on hierarchical macro-mesoporous Co3O4-SiO2 with enhanced photogenerated charges. J. Hazard. Mater. 2022, 430, 127414. [Google Scholar] [CrossRef]
- Yuan, M.; Xu, S.; Zhang, Q.; Zhao, B.; Feng, B.; Ji, K.; Yu, L.; Chen, W.; Hou, M.; Xu, Y.; et al. Bicompatible porous Co3O4 nanoplates with intrinsic tumor metastasis inhibition for multimodal imaging and DNA damage–mediated tumor synergetic photothermal/photodynamic therapy. Chem. Eng. J. 2020, 394, 124874. [Google Scholar] [CrossRef]
- Shahed, C.A.; Ahmad, F.; Günister, E.; Foudzi, F.M.; Ali, S.; Malik, K.; Harun, W.S.W. Antibacterial mechanism with consequent cytotoxicity of different reinforcements in biodegradable magnesium and zinc alloys: A review. J. Magnes. Alloys 2023, 11, 3038–3058. [Google Scholar] [CrossRef]
- Li, K.Q.; Xia, C.; Qiao, Y.Q.; Liu, X.Y. Dose-response relationships between copper and its biocompatibility/antibacterial activities. J. Trace Elem. Med. Biol. 2019, 55, 127–135. [Google Scholar] [CrossRef]
- Ning, C.; Wang, X.; Li, L.; Zhu, Y.; Li, M.; Yu, P.; Zhou, L.; Zhou, Z.; Chen, J.; Tan, G.; et al. Concentration Ranges of Antibacterial Cations for Showing the Highest Antibacterial Efficacy but the Least Cytotoxicity against Mammalian Cells: Implications for a New Antibacterial Mechanism. Chem. Res. Toxicol. 2015, 28, 1815–1822. [Google Scholar] [CrossRef] [PubMed]
- Zhao, X.; Cai, D.; Hu, J.; Nie, J.; Chen, D.; Qin, G.; Zhang, E. A high-hydrophilic Cu2O-TiO2/Ti2O3/TiO coating on Ti-5Cu alloy: Perfect antibacterial property and rapid endothelialization potential. Biomater. Adv. 2022, 140, 213044. [Google Scholar] [CrossRef]
- Wang, J.; Liang, M.F.; Pan, Y.; Sun, S.; Shen, T.; Wei, X.; Zhu, Y.; Liu, J.; Huang, Q. Control of surface composition and microstructure of nano super-hydrophilic TiO2-CuOy coatings through reactive sputtering to improve antibacterial ability, corrosion resistance, and biocompatibility. Appl. Surf. Sci. 2022, 578, 151893. [Google Scholar] [CrossRef]
- Guo, X.; Hu, B.; Wang, K.; Wang, H.; Li, B.; Guo, M.; Tian, Y.; Zhang, R.; Shi, S.; Han, Y. Cu embedded Co oxides and its fenton-like activity for metronidazole degradation over a wide pH range: Active sites of Cu doped Co3O4 with {112} exposed facet. Chem. Eng. J. 2022, 435, 132910. [Google Scholar] [CrossRef]
- Bandyopadhyay, A.; Mitra, I.; Goodman, S.B.; Kumar, M.; Bose, S. Improving biocompatibility for next generation of metallic implants. Prog. Mater Sci. 2023, 133, 101053. [Google Scholar] [CrossRef] [PubMed]
- Dias, L.F.G.; Abou-Hassan, A. Different applications, same story: Inspiring nanomedicine from photothermal catalysis to modulate the photothermal activity of nanomaterials through defects engineering. Coord. Chem. Rev. 2024, 507, 215751. [Google Scholar] [CrossRef]
- Zhang, J.; Chen, H.; Duan, X.; Sun, H.; Wang, S. Photothermal catalysis: From fundamentals to practical applications. Mater. Today 2023, 68, 234–253. [Google Scholar] [CrossRef]
- Yu, Q.; Liu, C.; Li, X.; Wang, C.; Wang, X.; Cao, H.; Zhao, M.; Wu, G.; Su, W.; Ma, T.; et al. N-doping activated defective Co3O4 as an efficient catalyst for low-temperature methane oxidation. Appl. Catal. B 2020, 269, 118757. [Google Scholar] [CrossRef]
- Zhou, J.; Yang, S.; Wan, W.; Chen, L.; Chen, J. Synergistic catalysis of mesoporous Cu/Co3O4 and surface oxygen vacancy for CO2 fixation to carbamates. J. Catal. 2023, 418, 178–189. [Google Scholar] [CrossRef]
- Jayaseelan, R.; Thennarasu, S.; Rajaji, P.; Nethaji, P.; Revathi, P.; Ramalingam, R.J.; Arokiyaraj, S. Long-life stability and high energy density storage MnCoPB-PDA/NF electrode material in hybrid supercapacitors. J. Energy Storage 2023, 72, 108303. [Google Scholar] [CrossRef]
- Dreyer, D.R.; Miller, D.J.; Freeman, B.D.; Paul, D.R.; Bielawski, C.W. Elucidating the Structure of Poly(dopamine). Langmuir 2012, 28, 6428–6435. [Google Scholar] [CrossRef] [PubMed]
- Li, Y.; Chen, T.; Zhao, S.; Wu, P.; Chong, Y.; Li, A.; Zhao, Y.; Chen, G.; Jin, X.; Qiu, Y.; et al. Engineering Cobalt Oxide with Coexisting Cobalt Defects and Oxygen Vacancies for Enhanced Catalytic Oxidation of Toluene. ACS Catal. 2022, 12, 4906–4917. [Google Scholar] [CrossRef]
- Wang, X.; Li, X.; Mu, J.; Fan, S.; Chen, X.; Wang, L.; Yin, Z.; Tadé, M.; Liu, S. Oxygen Vacancy-rich Porous Co3O4 Nanosheets toward Boosted NO Reduction by CO and CO Oxidation: Insights into the Structure–Activity Relationship and Performance Enhancement Mechanism. ACS Appl. Mater. Interfaces 2019, 11, 41988–41999. [Google Scholar] [CrossRef]
- Zhang, D.; Wang, M.; Wei, G.; Li, R.; Wang, N.; Yang, X.; Li, Z.; Zhang, Y.; Peng, Y. High visible light responsive ZnIn2S4/TiO2−x induced by oxygen defects to boost photocatalytic hydrogen evolution. Appl. Surf. Sci. 2023, 622, 156839. [Google Scholar] [CrossRef]
- Li, G.; Blake, G.R.; Palstra, T.T.M. Vacancies in functional materials for clean energy storage and harvesting: The perfect imperfection. Chem. Soc. Rev. 2017, 46, 1693–1706. [Google Scholar] [CrossRef] [PubMed]
- Singh, H.; Kumar, S.; Sharma, P.K. Tunable exciton-plasmon coupled resonances with Cu2+/Cu+ substitution in self-assembled CuS nanostructured films. Appl. Surf. Sci. 2023, 612, 155831. [Google Scholar] [CrossRef]
- Fornero, E.L.; Murgida, G.E.; Bosco, M.V.; Hernández Garrido, J.C.; Aguirre, A.; Calaza, F.C.; Stacchiola, D.; Verónica Ganduglia-Pirovano, M.; Bonivardi, A.L. CuGaO2 delafossite as a high-surface area model catalyst for Cu+-activated reactions. J. Catal. 2023, 427, 115107. [Google Scholar] [CrossRef]
- Zangmeister, R.A.; Morris, T.A.; Tarlov, M.J. Characterization of Polydopamine Thin Films Deposited at Short Times by Autoxidation of Dopamine. Langmuir 2013, 29, 8619–8628. [Google Scholar] [CrossRef] [PubMed]
- Liu, S.; Kang, L.; Hu, J.; Jung, E.; Zhang, J.; Jun, S.C.; Yamauchi, Y. Unlocking the Potential of Oxygen-Deficient Copper-Doped Co3O4 Nanocrystals Confined in Carbon as an Advanced Electrode for Flexible Solid-State Supercapacitors. ACS Energy Lett. 2021, 6, 3011–3019. [Google Scholar] [CrossRef]
- Sun, D.; Pang, X.; Cheng, Y.; Ming, J.; Xiang, S.; Zhang, C.; Lv, P.; Chu, C.; Chen, X.; Liu, G.; et al. Ultrasound-Switchable Nanozyme Augments Sonodynamic Therapy against Multidrug-Resistant Bacterial Infection. ACS Nano 2020, 14, 2063–2076. [Google Scholar] [CrossRef] [PubMed]
- Zhang, C.; Cao, M.; Ma, H.; Yu, C.; Li, K.; Yu, C.; Jiang, L. Morphology-Control Strategy of the Superhydrophobic Poly(Methyl Methacrylate) Surface for Efficient Bubble Adhesion and Wastewater Remediation. Adv. Funct. Mater. 2017, 27, 1702020. [Google Scholar] [CrossRef]
- Fan, H.; Wang, J.; Wu, P.; Zheng, L.; Xiang, J.; Liu, H.; Han, B.; Jiang, L. Hydrophobic ionic liquid tuning hydrophobic carbon to superamphiphilicity for reducing diffusion resistance in liquid-liquid catalysis systems. Chem 2021, 7, 1852–1869. [Google Scholar] [CrossRef]
- Chen, C.; Jiang, T.; Hou, J.; Zhang, T.; Zhang, G.; Zhang, Y.; Wang, X. Oxygen vacancies induced narrow band gap of BiOCl for efficient visible-light catalytic performance from double radicals. J. Mater. Sci. Technol. 2022, 114, 240–248. [Google Scholar] [CrossRef]
- Zhang, G.; Zhang, X.; Yang, Y.; Chi, R.; Shi, J.; Hang, R.; Huang, X.; Yao, X.; Chu, P.K.; Zhang, X. Dual light-induced in situ antibacterial activities of biocompatibleTiO2/MoS2/PDA/RGD nanorod arrays on titanium. Biomater. Sci. 2020, 8, 391–404. [Google Scholar] [CrossRef]
- Ciliveri, S.; Bandyopadhyay, A. Additively Manufactured SiO2 and Cu-Added Ti Implants for Synergistic Enhancement of Bone Formation and Antibacterial Efficacy. ACS Appl. Mater. Interfaces 2024, 16, 3106–3115. [Google Scholar] [CrossRef]
- Madiwal, V.; Khairnar, B.; Rajwade, J. Enhanced antibacterial activity and superior biocompatibility of cobalt-deposited titanium discs for possible use in implant dentistry. iScience 2024, 27, 108827. [Google Scholar] [CrossRef]
- Lei, W.; Ren, K.; Chen, T.; Chen, X.; Li, B.; Chang, H.; Ji, J. Polydopamine Nanocoating for Effective Photothermal Killing of Bacteria and Fungus upon Near-Infrared Irradiation. Adv. Mater. Interfaces 2016, 3, 1600767. [Google Scholar] [CrossRef]
- Rojas, E.R.; Billings, G.; Odermatt, P.D.; Auer, G.K.; Zhu, L.; Miguel, A.; Chang, F.; Weibel, D.B.; Theriot, J.A.; Huang, K.C. The outer membrane is an essential load-bearing element in Gram-negative bacteria. Nature 2018, 559, 617–621. [Google Scholar] [CrossRef] [PubMed]
- Lisboa, J.; Pereira, C.; Pinto, R.D.; Rodrigues, I.S.; Pereira, L.M.G.; Pinheiro, B.; Oliveira, P.; Pereira, P.J.B.; Azevedo, J.E.; Durand, D.; et al. Unconventional structure and mechanisms for membrane interaction and translocation of the NF-κB-targeting toxin AIP56. Nat. Commun. 2023, 14, 7431. [Google Scholar] [CrossRef]
- Schnaider, L.; Brahmachari, S.; Schmidt, N.W.; Mensa, B.; Shaham-Niv, S.; Bychenko, D.; Adler-Abramovich, L.; Shimon, L.J.W.; Kolusheva, S.; DeGrado, W.F.; et al. Self-assembling dipeptide antibacterial nanostructures with membrane disrupting activity. Nat. Commun. 2017, 8, 1365. [Google Scholar] [CrossRef] [PubMed]
- Acurio Cerda, K.; Kathol, M.; Purohit, G.; Zamani, E.; Morton, M.D.; Khalimonchuk, O.; Saha, R.; Dishari, S.K. Cationic Lignin as an Efficient and Biorenewable Antimicrobial Material. ACS Sustain. Chem. Eng. 2023, 11, 10364–10379. [Google Scholar] [CrossRef]
- Galbadage, T.; Liu, D.; Alemany, L.B.; Pal, R.; Tour, J.M.; Gunasekera, R.S.; Cirillo, J.D. Molecular Nanomachines Disrupt Bacterial Cell Wall, Increasing Sensitivity of Extensively Drug-Resistant Klebsiella pneumoniae to Meropenem. ACS Nano 2019, 13, 14377–14387. [Google Scholar] [CrossRef] [PubMed]
- Lee, H.; Lim, S.I.; Shin, S.-H.; Lim, Y.; Koh, J.W.; Yang, S. Conjugation of Cell-Penetrating Peptides to Antimicrobial Peptides Enhances Antibacterial Activity. ACS Omega 2019, 4, 15694–15701. [Google Scholar] [CrossRef]
- Li, Y.; Liu, X.; Tan, L.; Cui, Z.; Yang, X.; Zheng, Y.; Yeung, K.W.K.; Chu, P.K.; Wu, S. Rapid Sterilization and Accelerated Wound Healing Using Zn2+ and Graphene Oxide Modified g-C3N4 under Dual Light Irradiation. Adv. Funct. Mater. 2018, 28, 1800299. [Google Scholar] [CrossRef]
- Reiniers, M.J.; van Golen, R.F.; Bonnet, S.; Broekgaarden, M.; van Gulik, T.M.; Egmond, M.R.; Heger, M. Preparation and Practical Applications of 2′,7′-Dichlorodihydrofluorescein in Redox Assays. Anal. Chem. 2017, 89, 3853–3857. [Google Scholar] [CrossRef]
- Arakha, M.; Saleem, M.; Mallick, B.C.; Jha, S. The effects of interfacial potential on antimicrobial propensity of ZnO nanoparticle. Sci. Rep. 2015, 5, 9578. [Google Scholar] [CrossRef] [PubMed]
- Li, J.; Wu, X.; Shi, Q.; Li, C.; Chen, X. Effects of hydroxybutyl chitosan on improving immunocompetence and antibacterial activities. Mater. Sci. Eng. C 2019, 105, 110086. [Google Scholar] [CrossRef] [PubMed]
- Dediu, V.; Ghitman, J.; Gradisteanu Pircalabioru, G.; Chan, K.H.; Iliescu, F.S.; Iliescu, C. Trends in Photothermal Nanostructures for Antimicrobial Applications. Int. J. Mol. Sci. 2023, 24, 9375. [Google Scholar] [CrossRef]
- Yin, L.; Ma, H.; Fones Elizabeth, M.; Morris David, R.; Harwood Caroline, S. ATP Is a Major Determinant of Phototrophic Bacterial Longevity in Growth Arrest. mBio 2023, 14, e03609-22. [Google Scholar] [CrossRef] [PubMed]
- Bekale, L.A.; Sharma, D.; Bacacao, B.; Chen, J.; Maria, P.L.S. Eradication of bacterial persister cells by leveraging their low metabolic activity using adenosine triphosphate coated gold nanoclusters. Nano Today 2023, 51, 101895. [Google Scholar] [CrossRef]
- Bellanger, X.; Schneider, R.; Dezanet, C.; Arroua, B.; Balan, L.; Billard, P.; Merlin, C. Zn2+ leakage and photo-induced reactive oxidative species do not explain the full toxicity of ZnO core Quantum Dots. J. Hazard. Mater. 2020, 396, 122616. [Google Scholar] [CrossRef]
- Dissanayake, D.; Achola, L.A.; Kerns, P.; Rathnayake, D.; He, J.; Macharia, J.; Suib, S.L. Aerobic oxidative coupling of amines to imines by mesoporous copper aluminum mixed metal oxides via generation of Reactive Oxygen Species (ROS). Appl. Catal. B 2019, 249, 32–41. [Google Scholar] [CrossRef]
- Singh, N.; Sen Gupta, R.; Bose, S. A comprehensive review on singlet oxygen generation in nanomaterials and conjugated polymers for photodynamic therapy in the treatment of cancer. Nanoscale 2024, 16, 3243–3268. [Google Scholar] [CrossRef]
- Korupalli, C.; Kuo, C.-C.; Getachew, G.; Dirersa, W.B.; Wibrianto, A.; Rasal, A.S.; Chang, J.-Y. Multifunctional manganese oxide-based nanocomposite theranostic agent with glucose/light-responsive singlet oxygen generation and dual-modal imaging for cancer treatment. J. Colloid Interface Sci. 2023, 643, 373–384. [Google Scholar] [CrossRef]
- Liu, H.; Qu, X.; Tan, H.; Song, J.; Lei, M.; Kim, E.; Payne, G.F.; Liu, C. Role of polydopamine’s redox-activity on its pro-oxidant, radical-scavenging, and antimicrobial activities. Acta Biomater. 2019, 88, 181–196. [Google Scholar] [CrossRef] [PubMed]
- Jenkins, J.; Mantell, J.; Neal, C.; Gholinia, A.; Verkade, P.; Nobbs, A.H.; Su, B. Antibacterial effects of nanopillar surfaces are mediated by cell impedance, penetration and induction of oxidative stress. Nat. Commun. 2020, 11, 1626. [Google Scholar] [CrossRef] [PubMed]

Disclaimer/Publisher’s Note: The statements, opinions and data contained in all publications are solely those of the individual author(s) and contributor(s) and not of MDPI and/or the editor(s). MDPI and/or the editor(s) disclaim responsibility for any injury to people or property resulting from any ideas, methods, instructions or products referred to in the content. |
© 2024 by the authors. Licensee MDPI, Basel, Switzerland. This article is an open access article distributed under the terms and conditions of the Creative Commons Attribution (CC BY) license (https://creativecommons.org/licenses/by/4.0/).
Share and Cite
Qi, J.; Yu, M.; Liu, Y.; Zhang, J.; Li, X.; Ma, Z.; Sun, T.; Liu, S.; Qiu, Y. Polydopamine-Coated Copper-Doped Co3O4 Nanosheets Rich in Oxygen Vacancy on Titanium and Multimodal Synergistic Antibacterial Study. Materials 2024, 17, 2019. https://doi.org/10.3390/ma17092019
Qi J, Yu M, Liu Y, Zhang J, Li X, Ma Z, Sun T, Liu S, Qiu Y. Polydopamine-Coated Copper-Doped Co3O4 Nanosheets Rich in Oxygen Vacancy on Titanium and Multimodal Synergistic Antibacterial Study. Materials. 2024; 17(9):2019. https://doi.org/10.3390/ma17092019
Chicago/Turabian StyleQi, Jinteng, Miao Yu, Yi Liu, Junting Zhang, Xinyi Li, Zhuo Ma, Tiedong Sun, Shaoqin Liu, and Yunfeng Qiu. 2024. "Polydopamine-Coated Copper-Doped Co3O4 Nanosheets Rich in Oxygen Vacancy on Titanium and Multimodal Synergistic Antibacterial Study" Materials 17, no. 9: 2019. https://doi.org/10.3390/ma17092019
APA StyleQi, J., Yu, M., Liu, Y., Zhang, J., Li, X., Ma, Z., Sun, T., Liu, S., & Qiu, Y. (2024). Polydopamine-Coated Copper-Doped Co3O4 Nanosheets Rich in Oxygen Vacancy on Titanium and Multimodal Synergistic Antibacterial Study. Materials, 17(9), 2019. https://doi.org/10.3390/ma17092019






